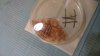

Hi everyone
I'd like to share my story here so that others may benefit from my experience and not make the same mistakes I have so far. I've been worried about hair loss ever since I was 18 or so, since my temples went bald very early on, and my father is completely bald so I knew the problem would only get worse as time went on. However, when I heard about a hair stem cell therapy offered by HASCI in the Netherlands, I got some hope. Previously I did not start any treatments because I know I will likely progress to NW6 or NW7 eventually. However, their claim - backed by research papers and celebrity testimonials - is that there is "virtually complete regrowth of the hairs in the donor area" which would allow for virtually limitless procedures. As such, I decided to tackle the problem early on and enjoy my youth with a full head of hair.
The first hair transplant was performed on 2013-03-12. Nine months after the surgery when final results were supposed to be visible, I was quite disappointed by the density though. Some redness was also still visible, which the doctors assured me would dissipate within a year after the surgery. I scheduled a second hair transplant for 2014-09-22 which was a year and a half after the first one. Each time they did about 1,600 grafts.
It has now been almost a year and a half since the second surgery and my hairline seems to be receding faster. Density in the temples is slightly higher than after the first surgery, but not what I was hoping/expecting. In fact, earlier this year I shaved my head for the first time because I was considering going for SMP as to avoid chasing after my receding hairline. Unfortunately, I found out that my scalp is just too red in the transplant area, it looks horrible especially under artificial lighting at certain angles. Since it has been a year and a half since the final surgery I am worried this might be permanent.
Recently, I've read some disturbing information about the HASCI clinic (summarized at http://www.hasci-exposed.com/analysis.html) and indicate that the claims made by Dr. Coen Gho at HASCI are deceitful.
Personally, I feel like I spent about 20,000 USD in vain and all I got were two poorly executed FUE treatments which left me with damaged skin and possibly limited my options for both going bald gracefully as well as having enough donor hair left to keep from going bald.
Right now I am consulting with some other surgeons to see what options I have left in terms of further hair transplants. I have several questions I'd like answered to decide on my next course of action. If HASCI has been deceitful about their claims and does not offer a solution I fully intend to file a lawsuit personally or a class-action lawsuit if other disadvantaged patients present themselves;
1. Is HASCI indeed a scam and if so, why hasn't this come to light yet after several years of them making claims and performing surgeries?
2. The fact that hairs seem to be at odd angles and pointing in different directions, is this due to my type of hair or were they implanted incorrectly?
3. Are any treatment options available for the redness in case I go the SMP route? Lasers seem to have their fair share of risk as well of further discoloration.
4. I trusted the doctor to decide on the shape of the hairline, but it seems to me that they chose one that does not look natural, is that correct?
== UPDATE 2016-02-18 ==
Today I had a Skype consultation with Dr. Gho. We discussed the topics I had doubts about.
REDNESS: Not explained
He says it's the first time he has ever seen redness lasting this long (just my luck) and rather than offering a solution for the redness, he offered to hide it with a free-of-charge third procedure to fill up the low density areas and gaps so the redness would no longer be visible using a new technique (pick & place).
NEW TECHNIQUE: Proof pending
He told me to watch a video (in Dutch) about the new technique which is the only information I've received so far. Supposedly the difference is that the hair is inserted at the time the perforation of the skin is made, and as such smaller punch size suffices and there is much quicker healing and less issues with blood and crusts. I'm waiting for more information by email since the video isn't exactly scientific evidence nor does it provide much information about the technique itself:
http://www.hasci.com/nl/nieuws-media/new-beauty-looks-seizoen-6-aflevering-4/
What I find a bit odd is that according to some videos on their website, the punch size in the recipient area is already as small as the one from the donor area (0.5 mm), so I don't understand how they would use an even smaller punch as the graft wouldn't even fit anymore.
DENSITY ISSUES: Not explained
I told him I had read the information on HASCI exposed and asked him to clarify why density with HASCI is apparently much lower than with normal FUE techniques. He sort of dodged the question saying that natural density will never be achieved, especially on a first pass. He followed this up saying that one wouldn't want too high density hair in the temples since as my natural hair starts thinning out, I'd have unnatural looking results. However, none of this explains why there seem to be consistent complaints about density with HST. I have seen some FUE results and often these look much denser on the first pass with less grafts than my two transplants for a total of 3,200 grafts.
ANGLES OF TRANSPLANTED HAIRS: Not explained
When I asked why the hairs were growing in different directions, he did not really provide an answer about the flaws in his current technique, but mentioned that with his new technique there should be more consistency in hair direction along with the other benefits.
DONOR REGENERATION & MULTIPLE HST'S: Proof pending
When I mentioned my main worry is the news report about Dean Saunders being depleted after three HST transplants, he declined that the donor area could have been depleted and said the doctor who did a body hair transplant on him didn't know what he was doing. He assured me that I would be able to do at least 8 and likely up to 11 total transplants and said that he has clients who have had 8 of these. I asked if I could see photos and speak to these people to hear about their experience with HASCI. He replied that he would ask them if their contact information could passed and said he could not send photos without permission. He sent me a photo of a donor area of someone who had had 4 transplants for a total of 6,000 grafts, which did not seem depleted. On forums I have read that people have between 3,000 and 7,000 grafts available for transplant in their donor area depending on original density and other factors, so I would still need to receive more information and references.
PARTIAL EXTRACTION: No proof provided
When I asked about the doubts raised at http://www.hasci-exposed.com/partial.html he told me that there is no way to really see the difference with just a photo, one would need to use a microscope to see the difference between normal FUE grafts and their HST grafts. It seems odd then that their presentation includes regular photos showing the difference rather than photos from under a microscope. In fact, the photos taken by HASCI Exposed seem to be of higher quality than those used in their presentation.
HAIRS PER GRAFT
I touched the subject of the number of hairs per graft being lower than the industry average. He said that in the temples one must use 1-hair grafts for natural results. I haven't done much research into the ratio of 1 vs 2 vs 3-hair grafts in the temples so this may be true, but for providing coverage on the remainder of my head I would be worried that two passes are required with HST and density is still disappointing.
CONCLUSION
I'm not convinced at all at this stage. I'll wait for his email to see what evidence and references he provides regarding his new technique but unless there is some very compelling information, I still feel he owes me a full refund for at least the surgeries since there is no evidence that I now have more hairs than I did before or that they even used the techniques they explain on their website. In fact they should be happy refunding just the surgeries considering the travel expenses I incurred, lost time/productivity and possibly costs for treatment of the redness they caused.
I'd like to share my story here so that others may benefit from my experience and not make the same mistakes I have so far. I've been worried about hair loss ever since I was 18 or so, since my temples went bald very early on, and my father is completely bald so I knew the problem would only get worse as time went on. However, when I heard about a hair stem cell therapy offered by HASCI in the Netherlands, I got some hope. Previously I did not start any treatments because I know I will likely progress to NW6 or NW7 eventually. However, their claim - backed by research papers and celebrity testimonials - is that there is "virtually complete regrowth of the hairs in the donor area" which would allow for virtually limitless procedures. As such, I decided to tackle the problem early on and enjoy my youth with a full head of hair.
The first hair transplant was performed on 2013-03-12. Nine months after the surgery when final results were supposed to be visible, I was quite disappointed by the density though. Some redness was also still visible, which the doctors assured me would dissipate within a year after the surgery. I scheduled a second hair transplant for 2014-09-22 which was a year and a half after the first one. Each time they did about 1,600 grafts.
It has now been almost a year and a half since the second surgery and my hairline seems to be receding faster. Density in the temples is slightly higher than after the first surgery, but not what I was hoping/expecting. In fact, earlier this year I shaved my head for the first time because I was considering going for SMP as to avoid chasing after my receding hairline. Unfortunately, I found out that my scalp is just too red in the transplant area, it looks horrible especially under artificial lighting at certain angles. Since it has been a year and a half since the final surgery I am worried this might be permanent.
Recently, I've read some disturbing information about the HASCI clinic (summarized at http://www.hasci-exposed.com/analysis.html) and indicate that the claims made by Dr. Coen Gho at HASCI are deceitful.
Personally, I feel like I spent about 20,000 USD in vain and all I got were two poorly executed FUE treatments which left me with damaged skin and possibly limited my options for both going bald gracefully as well as having enough donor hair left to keep from going bald.
Right now I am consulting with some other surgeons to see what options I have left in terms of further hair transplants. I have several questions I'd like answered to decide on my next course of action. If HASCI has been deceitful about their claims and does not offer a solution I fully intend to file a lawsuit personally or a class-action lawsuit if other disadvantaged patients present themselves;
1. Is HASCI indeed a scam and if so, why hasn't this come to light yet after several years of them making claims and performing surgeries?
2. The fact that hairs seem to be at odd angles and pointing in different directions, is this due to my type of hair or were they implanted incorrectly?
3. Are any treatment options available for the redness in case I go the SMP route? Lasers seem to have their fair share of risk as well of further discoloration.
4. I trusted the doctor to decide on the shape of the hairline, but it seems to me that they chose one that does not look natural, is that correct?
== UPDATE 2016-02-18 ==
Today I had a Skype consultation with Dr. Gho. We discussed the topics I had doubts about.
REDNESS: Not explained
He says it's the first time he has ever seen redness lasting this long (just my luck) and rather than offering a solution for the redness, he offered to hide it with a free-of-charge third procedure to fill up the low density areas and gaps so the redness would no longer be visible using a new technique (pick & place).
NEW TECHNIQUE: Proof pending
He told me to watch a video (in Dutch) about the new technique which is the only information I've received so far. Supposedly the difference is that the hair is inserted at the time the perforation of the skin is made, and as such smaller punch size suffices and there is much quicker healing and less issues with blood and crusts. I'm waiting for more information by email since the video isn't exactly scientific evidence nor does it provide much information about the technique itself:
http://www.hasci.com/nl/nieuws-media/new-beauty-looks-seizoen-6-aflevering-4/
What I find a bit odd is that according to some videos on their website, the punch size in the recipient area is already as small as the one from the donor area (0.5 mm), so I don't understand how they would use an even smaller punch as the graft wouldn't even fit anymore.
DENSITY ISSUES: Not explained
I told him I had read the information on HASCI exposed and asked him to clarify why density with HASCI is apparently much lower than with normal FUE techniques. He sort of dodged the question saying that natural density will never be achieved, especially on a first pass. He followed this up saying that one wouldn't want too high density hair in the temples since as my natural hair starts thinning out, I'd have unnatural looking results. However, none of this explains why there seem to be consistent complaints about density with HST. I have seen some FUE results and often these look much denser on the first pass with less grafts than my two transplants for a total of 3,200 grafts.
ANGLES OF TRANSPLANTED HAIRS: Not explained
When I asked why the hairs were growing in different directions, he did not really provide an answer about the flaws in his current technique, but mentioned that with his new technique there should be more consistency in hair direction along with the other benefits.
DONOR REGENERATION & MULTIPLE HST'S: Proof pending
When I mentioned my main worry is the news report about Dean Saunders being depleted after three HST transplants, he declined that the donor area could have been depleted and said the doctor who did a body hair transplant on him didn't know what he was doing. He assured me that I would be able to do at least 8 and likely up to 11 total transplants and said that he has clients who have had 8 of these. I asked if I could see photos and speak to these people to hear about their experience with HASCI. He replied that he would ask them if their contact information could passed and said he could not send photos without permission. He sent me a photo of a donor area of someone who had had 4 transplants for a total of 6,000 grafts, which did not seem depleted. On forums I have read that people have between 3,000 and 7,000 grafts available for transplant in their donor area depending on original density and other factors, so I would still need to receive more information and references.
PARTIAL EXTRACTION: No proof provided
When I asked about the doubts raised at http://www.hasci-exposed.com/partial.html he told me that there is no way to really see the difference with just a photo, one would need to use a microscope to see the difference between normal FUE grafts and their HST grafts. It seems odd then that their presentation includes regular photos showing the difference rather than photos from under a microscope. In fact, the photos taken by HASCI Exposed seem to be of higher quality than those used in their presentation.
HAIRS PER GRAFT
I touched the subject of the number of hairs per graft being lower than the industry average. He said that in the temples one must use 1-hair grafts for natural results. I haven't done much research into the ratio of 1 vs 2 vs 3-hair grafts in the temples so this may be true, but for providing coverage on the remainder of my head I would be worried that two passes are required with HST and density is still disappointing.
CONCLUSION
I'm not convinced at all at this stage. I'll wait for his email to see what evidence and references he provides regarding his new technique but unless there is some very compelling information, I still feel he owes me a full refund for at least the surgeries since there is no evidence that I now have more hairs than I did before or that they even used the techniques they explain on their website. In fact they should be happy refunding just the surgeries considering the travel expenses I incurred, lost time/productivity and possibly costs for treatment of the redness they caused.
Attachments
-
 2013-12-12 Low density nine months post op.JPG4.4 MB · Views: 6,645
2013-12-12 Low density nine months post op.JPG4.4 MB · Views: 6,645 -
 2016-01-03 Right profile with short hair.png370.3 KB · Views: 5,313
2016-01-03 Right profile with short hair.png370.3 KB · Views: 5,313 -
 2016-01-14 Left temple close-up.png1.6 MB · Views: 4,580
2016-01-14 Left temple close-up.png1.6 MB · Views: 4,580 -
 2016-01-14 Right temple close-up.png1.2 MB · Views: 4,385
2016-01-14 Right temple close-up.png1.2 MB · Views: 4,385 -
 2016-02-09 Hair color, texture and direction issues.jpg94 KB · Views: 4,510
2016-02-09 Hair color, texture and direction issues.jpg94 KB · Views: 4,510 -
2014-09-22 09.14.54.jpg1.4 MB · Views: 4,486
2014-09-22 09.14.54.jpg1.4 MB · Views: 4,486 -
 2013-03-12 HASCI #1 - Right.jpg56.2 KB · Views: 6,891
2013-03-12 HASCI #1 - Right.jpg56.2 KB · Views: 6,891
Last edited:

